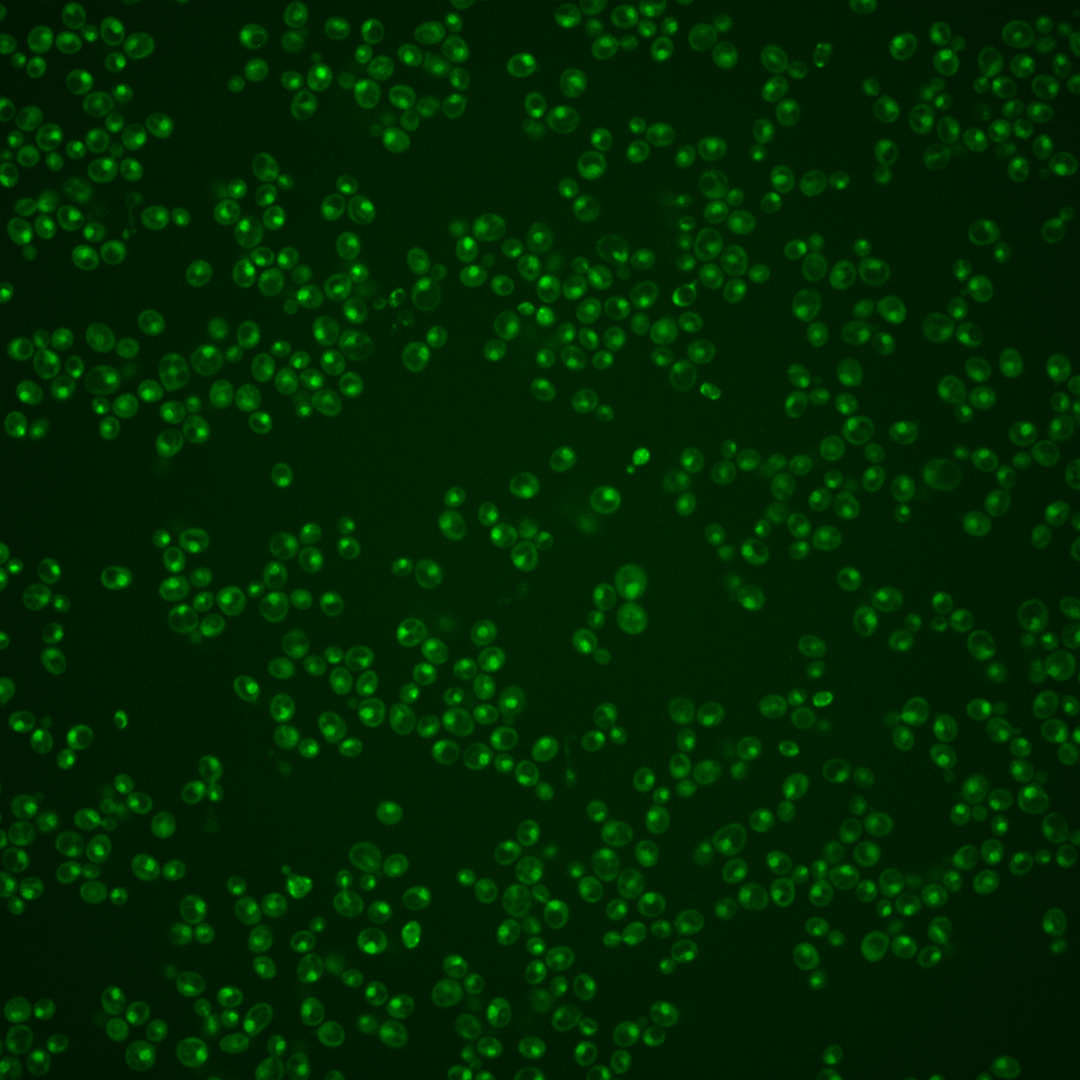
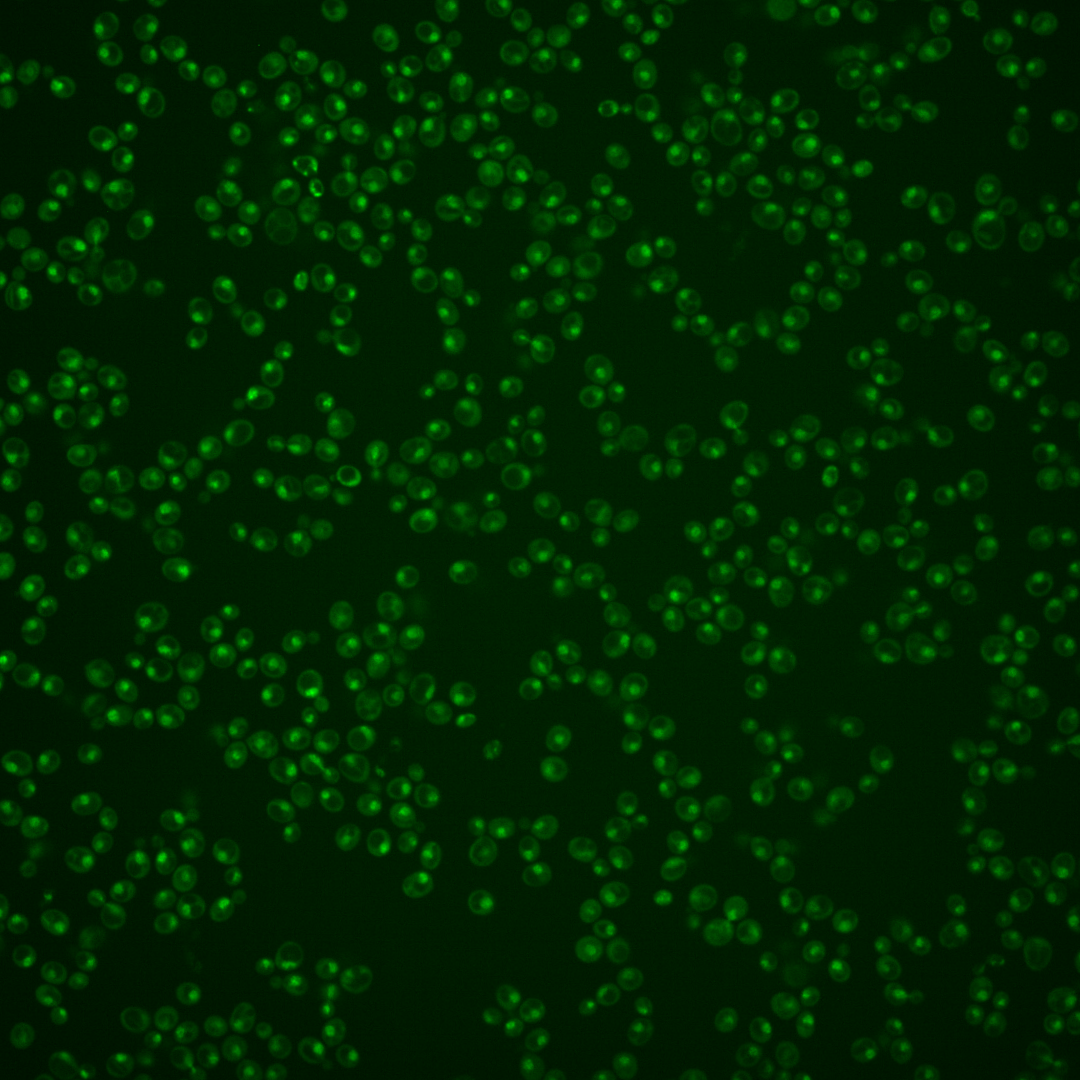
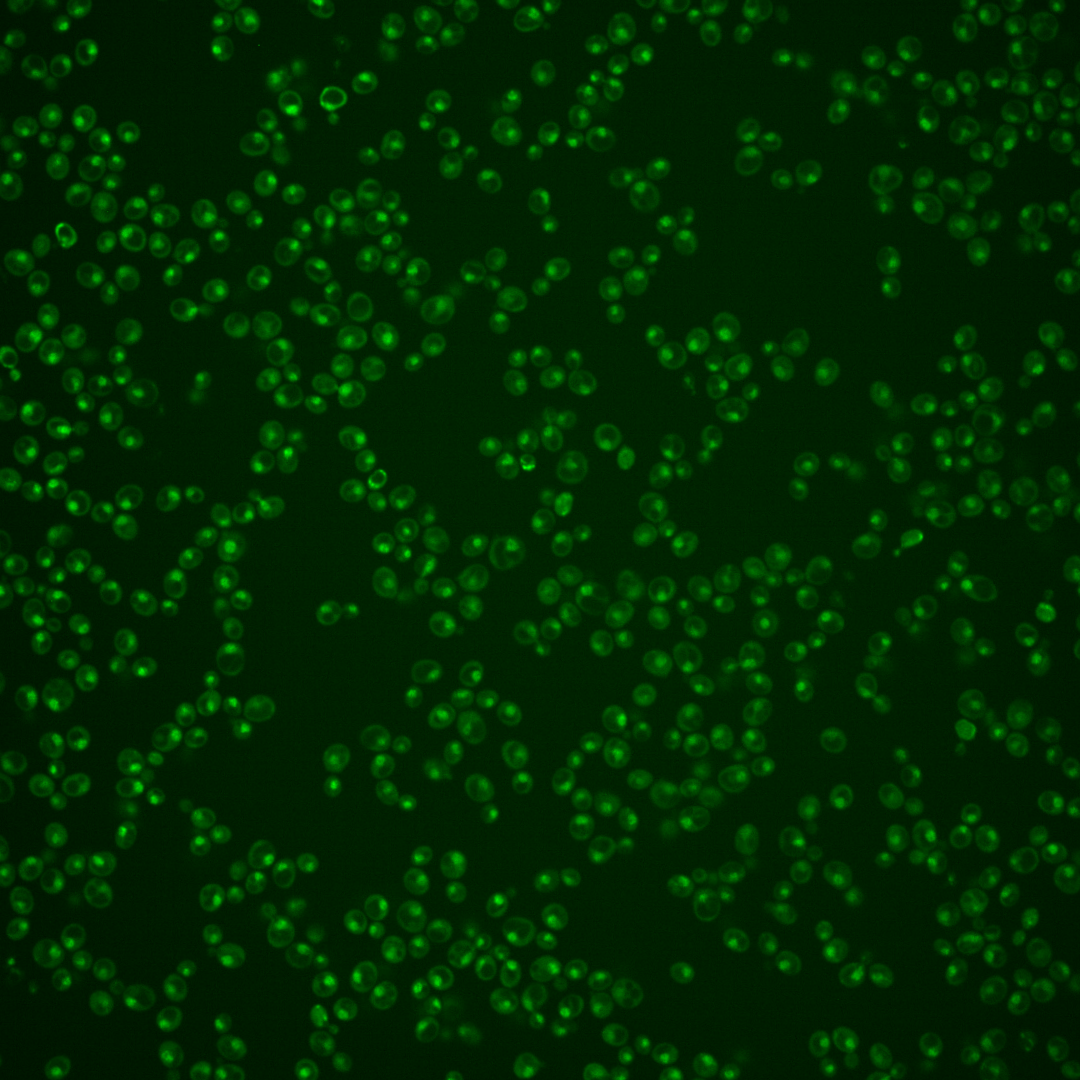
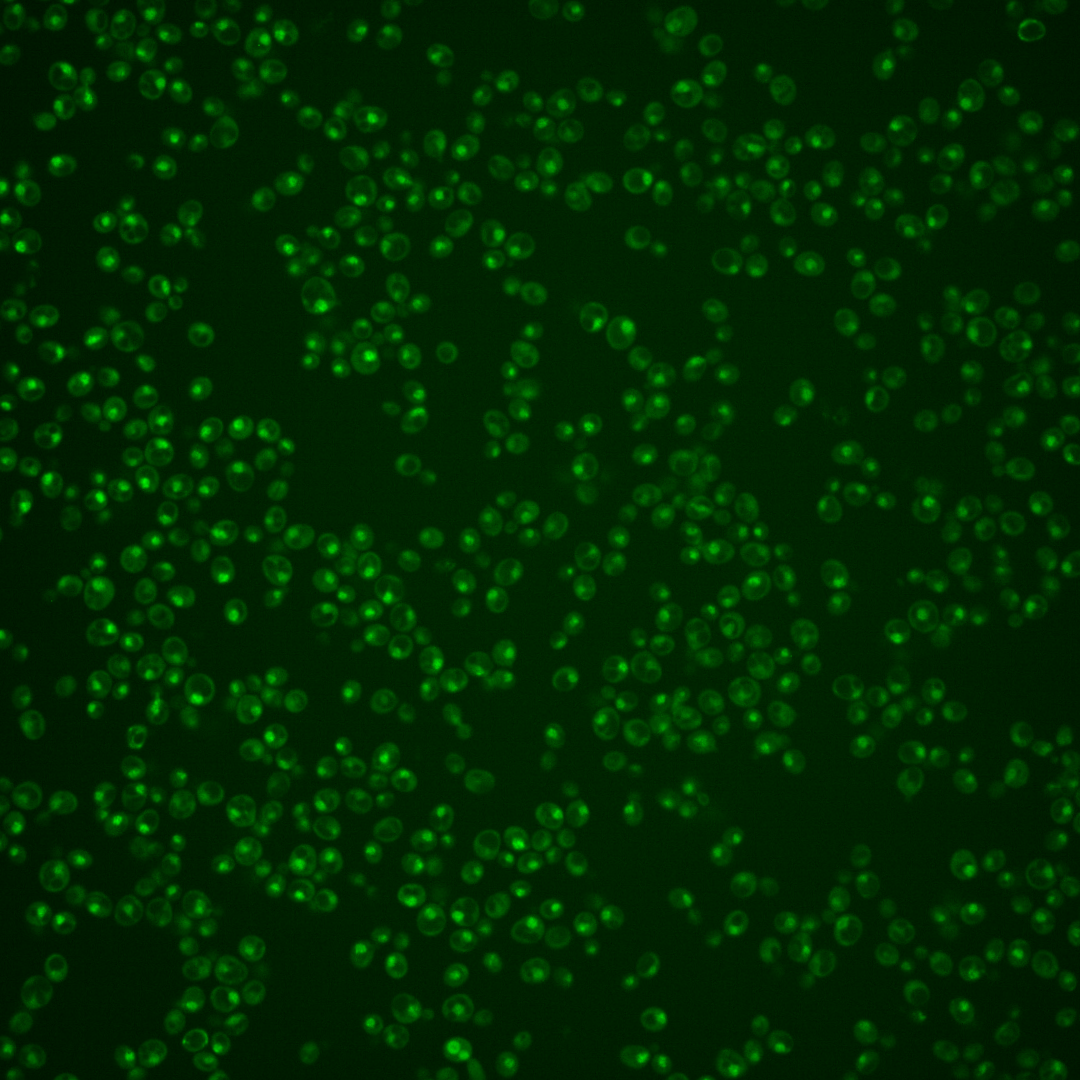
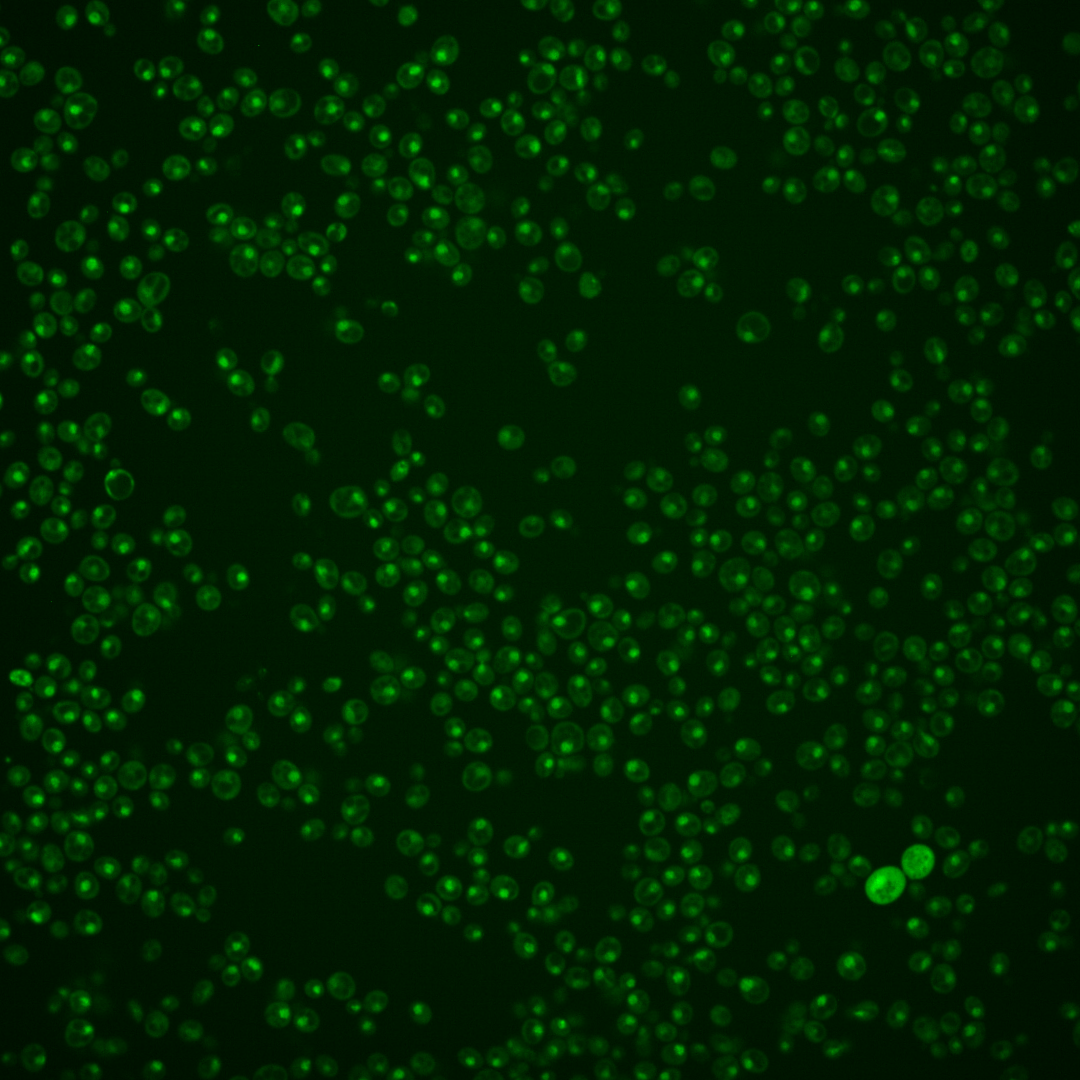
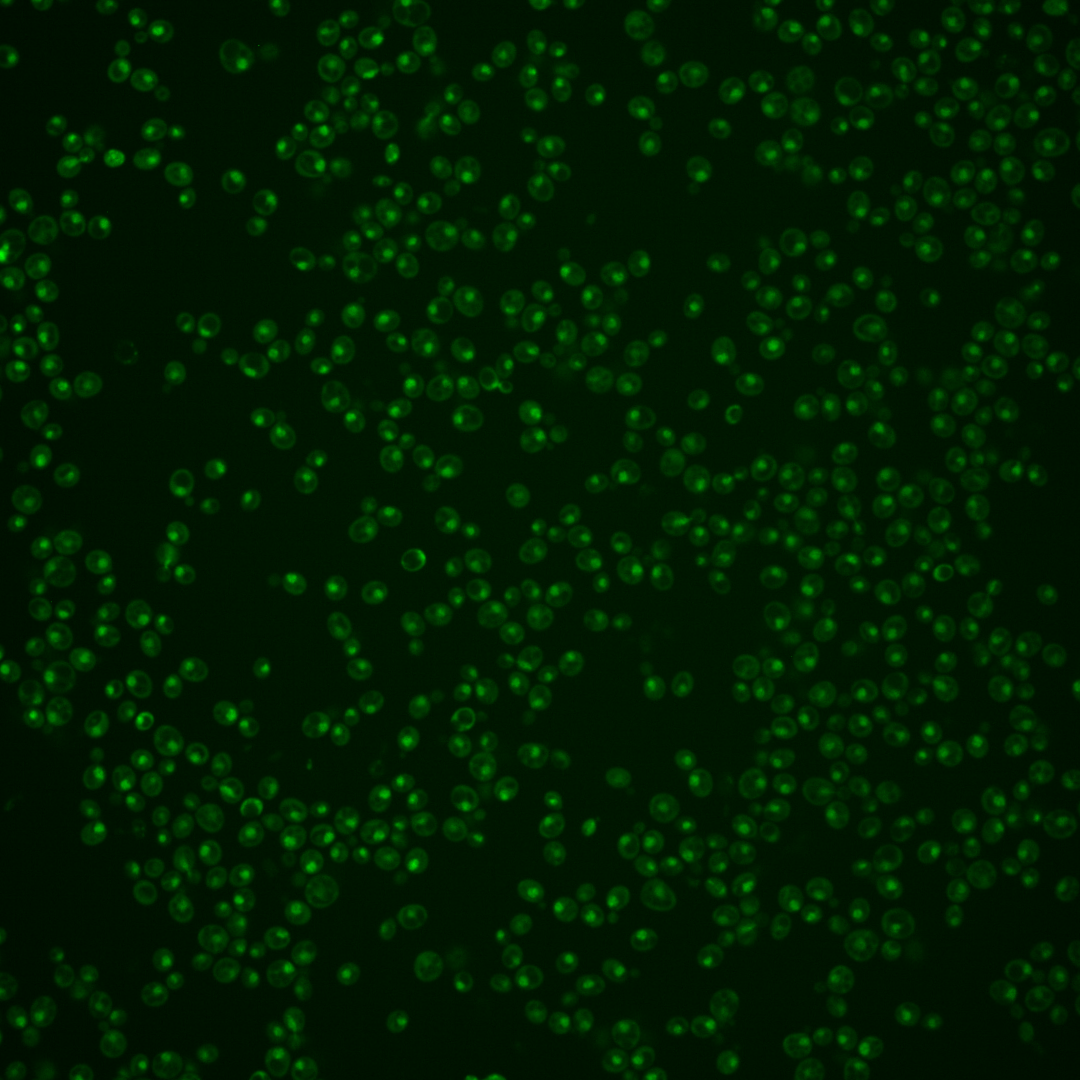

| Standard name | |
|---|---|
| Human Ortholog | |
| Description | Transcription factor; involved in regulation of cell cycle progression from G1 to S phase, forms a complex with Swi6p that binds to MluI cell cycle box regulatory element in promoters of DNA synthesis genes |
Micrographs




















































































Sub-cellular Localization
Yeast GFP Assignment
Protein Abundance
Localization Change
External localization resources
| ensLOC | DeepLoc | |||||||||||||||||||||||
|---|---|---|---|---|---|---|---|---|---|---|---|---|---|---|---|---|---|---|---|---|---|---|---|---|
| Localization | WT1 | WT2 | WT3 | RAP60 | RAP140 | RAP220 | RAP300 | RAP380 | RAP460 | RAP540 | RAP620 | RAP700 | HU80 | HU120 | HU160 | rpd3Δ_1 | rpd3Δ_2 | rpd3Δ_3 | WT1 | WT2 | WT3 | AF100 | AF140 | AF180 |
| Cortical Patches | 0 | 0 | 0 | 0 | 0 | 0 | 0 | 0 | 0 | 0 | 0 | 0 | 0 | 0 | 0 | 0 | 0 | 0 | 0 | 0 | 0 | 2 | 1 | 2 |
| Bud | 0 | 0 | 1 | 0 | 1 | 0 | 5 | 2 | 6 | 8 | 3 | 6 | 0 | 0 | 0 | 1 | 0 | 0 | 0 | 2 | 3 | 1 | 4 | 10 |
| Bud Neck | 0 | 0 | 2 | 1 | 2 | 3 | 2 | 5 | 1 | 3 | 3 | 4 | 0 | 0 | 0 | 0 | 0 | 0 | 0 | 0 | 1 | 1 | 2 | 4 |
| Bud Site | 0 | 0 | 1 | 5 | 2 | 16 | 18 | 6 | 18 | 22 | 25 | 14 | 1 | 0 | 0 | 0 | 0 | 0 | – | – | – | – | – | – |
| Cell Periphery | 0 | 0 | 0 | 0 | 0 | 0 | 0 | 0 | 0 | 0 | 0 | 0 | 1 | 0 | 0 | 0 | 0 | 0 | 0 | 0 | 0 | 0 | 0 | 0 |
| Cytoplasm | 3 | 9 | 12 | 7 | 19 | 20 | 26 | 23 | 11 | 10 | 7 | 9 | 31 | 25 | 37 | 8 | 1 | 3 | 0 | 2 | 2 | 1 | 2 | 2 |
| Endoplasmic Reticulum | 0 | 2 | 1 | 0 | 0 | 1 | 0 | 0 | 0 | 0 | 0 | 0 | 1 | 0 | 2 | 1 | 1 | 1 | 0 | 0 | 0 | 1 | 2 | 3 |
| Endosome | 0 | 1 | 1 | 0 | 1 | 0 | 1 | 0 | 1 | 0 | 0 | 0 | 0 | 4 | 3 | 0 | 1 | 2 | 2 | 3 | 2 | 3 | 11 | 13 |
| Golgi | 0 | 0 | 0 | 0 | 0 | 0 | 0 | 0 | 0 | 0 | 0 | 0 | 0 | 1 | 0 | 0 | 0 | 0 | 2 | 3 | 0 | 0 | 1 | 2 |
| Mitochondria | 24 | 41 | 20 | 11 | 16 | 101 | 142 | 72 | 200 | 230 | 133 | 73 | 17 | 1 | 7 | 3 | 3 | 5 | 3 | 2 | 3 | 4 | 5 | 4 |
| Nucleus | 205 | 221 | 372 | 204 | 308 | 348 | 403 | 352 | 308 | 300 | 190 | 201 | 273 | 210 | 237 | 55 | 49 | 18 | 187 | 222 | 334 | 120 | 159 | 145 |
| Nuclear Periphery | 1 | 0 | 3 | 0 | 2 | 8 | 8 | 2 | 6 | 6 | 1 | 2 | 8 | 1 | 0 | 1 | 0 | 0 | 0 | 0 | 1 | 1 | 1 | 2 |
| Nucleolus | 18 | 5 | 3 | 4 | 6 | 23 | 21 | 22 | 48 | 49 | 50 | 30 | 29 | 12 | 23 | 1 | 7 | 2 | 18 | 16 | 25 | 44 | 55 | 51 |
| Peroxisomes | 0 | 0 | 0 | 0 | 0 | 0 | 0 | 0 | 0 | 0 | 0 | 0 | 0 | 3 | 0 | 0 | 0 | 0 | 0 | 0 | 0 | 0 | 0 | 1 |
| SpindlePole | 2 | 3 | 28 | 8 | 23 | 8 | 22 | 29 | 10 | 10 | 5 | 6 | 2 | 4 | 2 | 1 | 0 | 0 | 0 | 2 | 7 | 4 | 6 | 14 |
| Vac/Vac Membrane | 0 | 5 | 2 | 0 | 5 | 2 | 3 | 3 | 1 | 2 | 0 | 1 | 2 | 4 | 6 | 4 | 3 | 1 | 7 | 7 | 24 | 20 | 30 | 27 |
| Unique Cell Count | 219 | 252 | 392 | 217 | 348 | 413 | 492 | 422 | 397 | 407 | 237 | 255 | 318 | 247 | 297 | 71 | 57 | 25 | 226 | 267 | 411 | 212 | 290 | 299 |
| Labelled Cell Count | 253 | 287 | 446 | 240 | 385 | 530 | 651 | 516 | 610 | 640 | 417 | 346 | 365 | 265 | 317 | 75 | 65 | 32 | 226 | 267 | 411 | 212 | 290 | 299 |
Yeast GFP Assignment
Protein Abundance
| Screen | WT1 | WT2 | WT3 | RAP60 | RAP140 | RAP220 | RAP300 | RAP380 | RAP460 | RAP540 | RAP620 | RAP700 | HU80 | HU120 | HU160 | rpd3Δ_1 | rpd3Δ_2 | rpd3Δ_3 | AF100 | AF140 | AF180 |
|---|---|---|---|---|---|---|---|---|---|---|---|---|---|---|---|---|---|---|---|---|---|
| Mean Cell GFP Intensity (1e-4) | 5.3 | 5.4 | 5.5 | 5.2 | 5.7 | 4.6 | 4.8 | 5.1 | 4.1 | 3.9 | 3.8 | 4.5 | 5.9 | 6.8 | 5.9 | 7.7 | 8.2 | 7.2 | 6.2 | 5.3 | 5.6 |
| Std Deviation (1e-4) | 0.8 | 0.8 | 0.8 | 1.3 | 1.2 | 1.3 | 1.2 | 1.3 | 0.7 | 0.7 | 1.0 | 1.1 | 2.3 | 4.1 | 2.0 | 2.2 | 1.5 | 1.7 | 4.4 | 2.0 | 1.7 |
| Intensity Change (Log2) | – | – | – | -0.09 | 0.05 | -0.26 | -0.2 | -0.13 | -0.44 | -0.5 | -0.55 | -0.31 | 0.09 | 0.29 | 0.09 | 0.46 | 0.56 | 0.37 | 0.17 | -0.05 | 0.01 |
Localization Change
| Localization | RAP60 | RAP140 | RAP220 | RAP300 | RAP380 | RAP460 | RAP540 | RAP620 | RAP700 | HU80 | HU120 | HU160 | rpd3Δ_1 | rpd3Δ_2 | rpd3Δ_3 |
|---|---|---|---|---|---|---|---|---|---|---|---|---|---|---|---|
| Cortical Patches | 0 | 0 | 0 | 0 | 0 | 0 | 0 | 0 | 0 | 0 | 0 | 0 | 0 | 0 | 0 |
| Bud | 0 | 0 | 0 | 0 | 0 | 0 | 0 | 0 | 0 | 0 | 0 | 0 | 0 | 0 | 0 |
| Bud Neck | 0 | 0 | 0 | 0 | 0 | 0 | 0 | 0 | 0 | 0 | 0 | 0 | 0 | 0 | 0 |
| Bud Site | 0 | 0 | 0 | 0 | 0 | 0 | 0 | 0 | 0 | 0 | 0 | 0 | 0 | 0 | 0 |
| Cell Periphery | 0 | 0 | 0 | 0 | 0 | 0 | 0 | 0 | 0 | 0 | 0 | 0 | 0 | 0 | 0 |
| Cytoplasm | 0.1 | 1.6 | 1.3 | 1.6 | 1.7 | -0.2 | -0.5 | -0.1 | 0.3 | 3.7 | 3.7 | 4.8 | 0 | 0 | 0 |
| Endoplasmic Reticulum | 0 | 0 | 0 | 0 | 0 | 0 | 0 | 0 | 0 | 0 | 0 | 0 | 0 | 0 | 0 |
| Endosome | 0 | 0 | 0 | 0 | 0 | 0 | 0 | 0 | 0 | 0 | 0 | 0 | 0 | 0 | 0 |
| Golgi | 0 | 0 | 0 | 0 | 0 | 0 | 0 | 0 | 0 | 0 | 0 | 0 | 0 | 0 | 0 |
| Mitochondria | 0 | -0.3 | 0 | 0 | 5.4 | 0 | 0 | 0 | 0 | 0.1 | -3.2 | -1.8 | 0 | 0 | 0 |
| Nucleus | -0.5 | -3.2 | -4.9 | -5.8 | -5.2 | -7.0 | -8.2 | -5.8 | -6.3 | -4.2 | -4.3 | -6.1 | -5.0 | -2.6 | -4.5 |
| Nuclear Periphery | 0 | 0 | 0 | 0 | 0 | 0 | 0 | 0 | 0 | 0 | 0 | 0 | 0 | 0 | 0 |
| Nucleolus | 0 | 0 | 0 | 0 | 3.7 | 0 | 0 | 0 | 0 | 5.3 | 3.3 | 4.8 | 0 | 0 | 0 |
| Peroxisomes | 0 | 0 | 0 | 0 | 0 | 0 | 0 | 0 | 0 | 0 | 0 | 0 | 0 | 0 | 0 |
| SpindlePole | -1.7 | -0.3 | 0 | 0 | -0.2 | 0 | 0 | 0 | 0 | -4.3 | -3.1 | -4.1 | 0 | 0 | 0 |
| Vacuole | 0 | 0 | 0 | 0 | 0 | 0 | 0 | 0 | 0 | 0 | 0 | 0 | 0 | 0 | 0 |
External localization resources
Images






























Protein Concentration and Protein Localization Data
| R1 | R2 | R3 | ||||||||||||||||
|---|---|---|---|---|---|---|---|---|---|---|---|---|---|---|---|---|---|---|
| G1 Pre-START | G1 Post-START | S/G2 | Metaphase | Anaphase | Telophase | G1 Pre-START | G1 Post-START | S/G2 | Metaphase | Anaphase | Telophase | G1 Pre-START | G1 Post-START | S/G2 | Metaphase | Anaphase | Telophase | |
| Concentration | 3.7391 | 3.6222 | 3.4762 | 2.8641 | 3.2457 | 3.4165 | 2.2983 | 1.8755 | 1.8643 | 1.732 | 1.6846 | 1.7059 | 1.7602 | 1.0499 | 0.7854 | 1.3447 | 0.873 | 1.0108 |
| Actin | 0.0365 | 0.0006 | 0.0063 | 0 | 0.0105 | 0.002 | 0.0287 | 0.0002 | 0.0119 | 0.0391 | 0.0052 | 0.0005 | 0.0489 | 0 | 0.0121 | 0.001 | 0.0051 | 0.0007 |
| Bud | 0.0007 | 0.0001 | 0.0002 | 0 | 0.0002 | 0.0002 | 0.0005 | 0.0001 | 0.0013 | 0.0003 | 0.0003 | 0 | 0.0005 | 0 | 0.002 | 0.0017 | 0.0004 | 0.0001 |
| Bud Neck | 0.0028 | 0.0002 | 0.0009 | 0.0001 | 0.0008 | 0.0017 | 0.0026 | 0.0002 | 0.001 | 0.0008 | 0.0019 | 0.0006 | 0.0012 | 0.0001 | 0.0002 | 0.0012 | 0.0002 | 0.0007 |
| Bud Periphery | 0.0019 | 0.0001 | 0.0006 | 0 | 0.0003 | 0.0001 | 0.0009 | 0.0001 | 0.002 | 0.0006 | 0.0021 | 0.0002 | 0.0008 | 0 | 0.0036 | 0.0015 | 0.0006 | 0.0001 |
| Bud Site | 0.0128 | 0.0033 | 0.0009 | 0 | 0.0008 | 0.0008 | 0.0098 | 0.0025 | 0.0114 | 0.0017 | 0.0007 | 0.0001 | 0.0032 | 0.0001 | 0.0031 | 0.0011 | 0.0007 | 0.0001 |
| Cell Periphery | 0.0017 | 0 | 0.0003 | 0 | 0.0001 | 0.0001 | 0.0003 | 0 | 0.0003 | 0.0002 | 0.0008 | 0 | 0.0002 | 0 | 0.0001 | 0.0002 | 0.0001 | 0 |
| Cytoplasm | 0.0027 | 0.0002 | 0.0058 | 0.0001 | 0.0005 | 0.0068 | 0.0024 | 0.0001 | 0.0028 | 0.0003 | 0.0003 | 0.0001 | 0.0148 | 0.0001 | 0.0002 | 0.0793 | 0.0005 | 0.0003 |
| Cytoplasmic Foci | 0.0164 | 0.0019 | 0.0036 | 0 | 0.0102 | 0.0018 | 0.0122 | 0.0002 | 0.0069 | 0.0032 | 0.0019 | 0.0008 | 0.0183 | 0 | 0.0035 | 0.0019 | 0.008 | 0.0041 |
| Eisosomes | 0.001 | 0 | 0.0002 | 0 | 0.0001 | 0 | 0.0003 | 0 | 0.0001 | 0.0002 | 0.0002 | 0 | 0.0005 | 0 | 0.0001 | 0 | 0.0001 | 0 |
| Endoplasmic Reticulum | 0.0077 | 0 | 0.0052 | 0 | 0.0004 | 0.0004 | 0.0034 | 0 | 0.001 | 0.0004 | 0.0026 | 0.0004 | 0.0032 | 0 | 0.0001 | 0.0005 | 0.0015 | 0.0001 |
| Endosome | 0.0188 | 0.0015 | 0.0082 | 0 | 0.014 | 0.0062 | 0.0204 | 0.0003 | 0.0102 | 0.0135 | 0.0173 | 0.0035 | 0.0178 | 0 | 0.0015 | 0.0016 | 0.0292 | 0.0043 |
| Golgi | 0.0084 | 0.0018 | 0.006 | 0 | 0.0065 | 0.0025 | 0.0124 | 0.0004 | 0.0049 | 0.0047 | 0.0159 | 0.0027 | 0.0125 | 0 | 0.0016 | 0.0012 | 0.01 | 0.001 |
| Lipid Particles | 0.0273 | 0.0008 | 0.0036 | 0 | 0.0273 | 0.005 | 0.0173 | 0 | 0.0126 | 0.0049 | 0.0091 | 0.0013 | 0.0191 | 0 | 0.0018 | 0 | 0.0235 | 0.0031 |
| Mitochondria | 0.0161 | 0.0009 | 0.0138 | 0.0001 | 0.0058 | 0.0007 | 0.0081 | 0.0075 | 0.0133 | 0.0124 | 0.0288 | 0.0037 | 0.0183 | 0.0001 | 0.0017 | 0.0016 | 0.011 | 0.0005 |
| None | 0.0022 | 0 | 0.01 | 0 | 0.0003 | 0.0017 | 0.0023 | 0 | 0.0005 | 0.0002 | 0.0005 | 0.0001 | 0.0071 | 0 | 0.0002 | 0.0003 | 0.0007 | 0.0003 |
| Nuclear Periphery | 0.0077 | 0.0008 | 0.0044 | 0.0016 | 0.0019 | 0.001 | 0.0187 | 0.0008 | 0.0052 | 0.0011 | 0.0314 | 0.0116 | 0.007 | 0.0008 | 0.0095 | 0.0005 | 0.0085 | 0.0009 |
| Nucleolus | 0.0321 | 0.0236 | 0.0201 | 0.0173 | 0.1135 | 0.0899 | 0.0167 | 0.0192 | 0.019 | 0.0084 | 0.133 | 0.064 | 0.0238 | 0.0255 | 0.0219 | 0.0658 | 0.0653 | 0.0577 |
| Nucleus | 0.7697 | 0.9623 | 0.896 | 0.9779 | 0.7896 | 0.8724 | 0.8271 | 0.9674 | 0.8856 | 0.9015 | 0.7183 | 0.9043 | 0.7796 | 0.9717 | 0.9244 | 0.8387 | 0.7663 | 0.9203 |
| Peroxisomes | 0.0213 | 0.0004 | 0.006 | 0 | 0.0029 | 0.0011 | 0.0074 | 0.0001 | 0.002 | 0.0014 | 0.0008 | 0.0003 | 0.0101 | 0 | 0.0107 | 0.0001 | 0.0631 | 0.0028 |
| Punctate Nuclear | 0.0078 | 0.0011 | 0.0054 | 0.0028 | 0.0137 | 0.0053 | 0.0041 | 0.0006 | 0.0046 | 0.0003 | 0.0168 | 0.0041 | 0.0108 | 0.0016 | 0.0006 | 0.0009 | 0.0024 | 0.0025 |
| Vacuole | 0.0033 | 0.0002 | 0.0016 | 0 | 0.0004 | 0.0003 | 0.0026 | 0.0002 | 0.0022 | 0.0034 | 0.0049 | 0.0005 | 0.0011 | 0 | 0.0007 | 0.0006 | 0.0012 | 0.0002 |
| Vacuole Periphery | 0.0012 | 0.0001 | 0.0009 | 0 | 0.0003 | 0.0001 | 0.0019 | 0.0001 | 0.0013 | 0.0014 | 0.007 | 0.0013 | 0.0009 | 0 | 0.0002 | 0.0002 | 0.0018 | 0.0002 |
Sequencing Data
| R1 | R2 | |||||||||
|---|---|---|---|---|---|---|---|---|---|---|
| G1 Post-START | S/G2 | Metaphase | Anaphase | Telophase | G1 Post-START | S/G2 | Metaphase | Anaphase | Telophase | |
| Gene Expression | 13.6713 | 12.6155 | 8.7762 | 14.5606 | 16.2959 | 12.7822 | 17.0406 | 18.1599 | 13.1306 | 17.022 |
| Translational Efficiency | 1.0072 | 1.2706 | 1.192 | 0.7497 | 0.7357 | 1.0597 | 0.9383 | 0.7876 | 0.8334 | 0.7027 |
Hit Data
| Dataset | Hit |
|---|---|
| Protein Concentration | ✘ |
| Protein Localization | ✘ |
| Gene Expression | ✘ |
| Translational Efficiency | ✔ |
Endocytosis
| Temp | Actin Patch (Sac6-tdTomato) | Cortical Patch (Sla1-GFP) | Late Endosome (Snf7-GFP) | Vacuole (Vph1-GFP) |
|---|---|---|---|---|
| 37℃ | ||||
| RT |
Cell Cycle Omics
CYCLoPs (Mbp1-GFP)
| Gene / Allele | Actin Patch (Sac6-tdTomato) | Cortical Patch (Sla1-GFP) | Late Endosome (Snf7-GFP) | Vacuole (Sac6-tdTomato) |
|---|
| Gene | Images |
|---|
| Gene | Images |
|---|
Images are not yet available
Images are not yet available